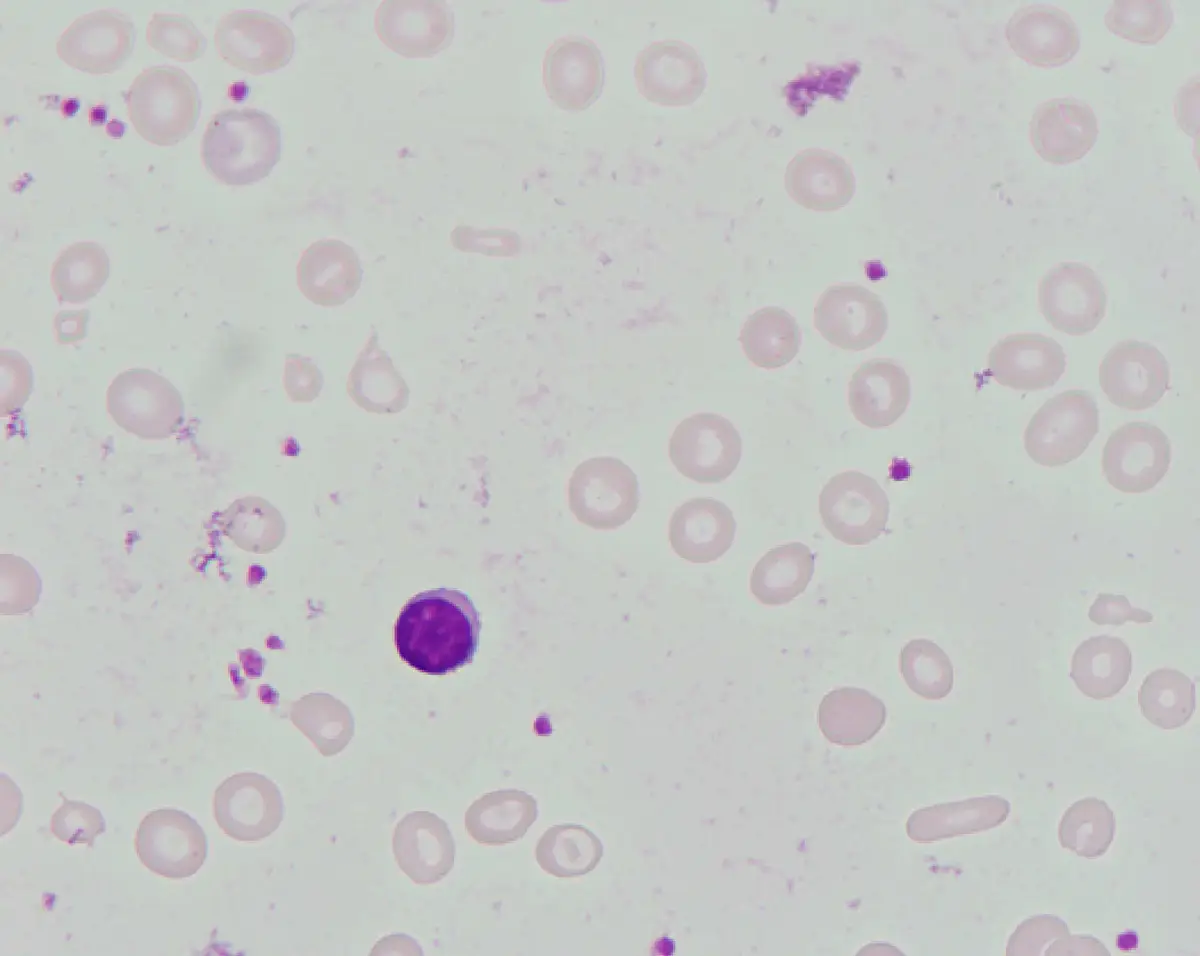
圖片

108年:醫學三(1)
⼀位 46 歲女性因為常常頭暈,爬樓梯時感到很喘⽽來醫院求診。⾝體檢查除臉⾊與結膜蒼⽩之外,並無其他明顯異常。患者⾎壓 106/76 mmHg ,脈搏每分鐘 72 次,規則⼼跳,無發燒,亦無體重減輕或是食慾降低的現象。⾎液數據顯⽰⾎紅素 7.6 g/dL ,⽩⾎球 4,030/μL ,無異常分類,⾎⼩板 418,000/μL ,MCV 74.8 fL (參考區間 80 ~100 ), ferritin 3.84 ng/mL (參考區間 28 ~365 ), serum iron 10 μg/dL (參考區間 51 ~209 ),TIBC (total iron binding capacity )459 μg/dL (參考區間 268 ~593 )。⾎液抹片如下圖所⽰。有關這位病⼈最可能的疾病之描述,下列何者錯誤?
A此類病⼈的⾎液中的 reticulocyte counts 常是降低的
B此類病⼈的骨髓中的 sideroblast 比例常是降低的
C此類病⼈的紅⾎球中的 protoporphyrin 量常是降低的
D此類病⼈的 red cell distribution width (RDW )index 常是增加的
詳細解析
本題觀念:
本題考查缺鐵性貧血(iron deficiency anemia, IDA)的實驗室特徵,為反向題(問「何者錯誤」)。IDA 是全球最常見的貧血類型,因體內鐵儲存耗盡導致血紅素合成不足,造成小球型低色素性貧血(microcytic hypochromic anemia)。本患者具有典型 IDA 四大實驗室指標:Hb 7.6 g/dL(降低)、MCV 74.8 fL(<80 fL,微球型)、ferritin 3.84 ng/mL(<15 ng/mL,鐵儲存耗盡)、serum iron 10 μg/dL(降低)、TIBC 459 μg/dL(升高),診斷明確。
影像分析:
血液抹片(peripheral blood smear,Wright-Giemsa 染色)所見:
紅血球形態異常(為主要所見):
- 微球型紅血球(microcytes):視野中可見多個紅血球體積明顯縮小,直徑遠小於正常淋巴球核(正常 RBC 直徑約等於淋巴球核,此圖 RBC 明顯偏小)
- 低色素性紅血球(hypochromic RBCs):紅血球中央蒼白區(central pallor)顯著擴大,超過細胞直徑的 1/3(正常 <1/3),僅留薄薄一圈橘紅色血紅素環,為 IDA 的病理特徵
- 大小不等症(anisocytosis):視野中紅血
...(解析預覽)...
![醫師[2] - 貧血及紅血球疾病 - AI 圖文解析預覽](/_next/image?url=https%3A%2F%2Fbgvxfcrmbdvefjhuvrmt.supabase.co%2Fstorage%2Fv1%2Fobject%2Fpublic%2Fvisual-explanations%2F683%2F45446_t2d061r5c.webp&w=3840&q=75)
升級 VIP 解鎖圖文解析